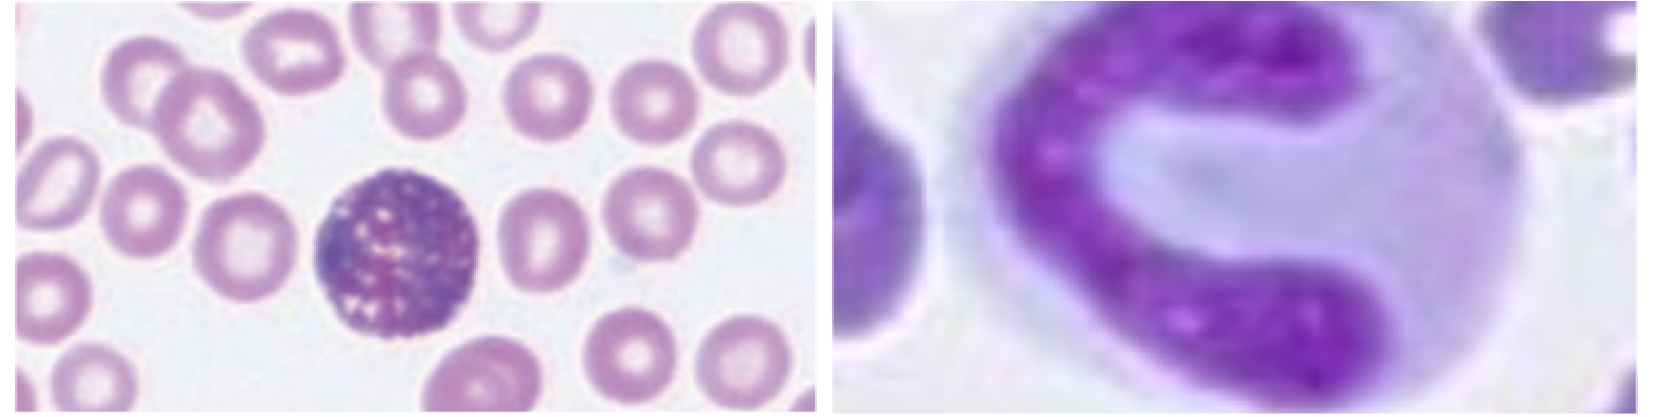
Bilde av eosinofil granulocytt hos hund og band neutrofil hos katt

Fremtidens komplette løsning for hematologi på din klinikk

Triolab presenterer en ny måte å analysere og tolke hematologiske prøver på, optimalisert og forenklet med hjelp av AI. Dra nytte av synergien mellom to unike og innovative løsninger fra Zoetis Diagnostics, for en nøykatig og komplett hematologidiagnostikk på din klinikk.
Vetscan Opticell™: hematologi-instrument uten reagenspakke, med alt-i-ett-testkassett
Unik testkassett-teknologi for en komplett hematologisk status, inkludert reticulocytter, trombocytter og med en 5-parts differensialtelling. Teller også antall trombocytter i eventuelle aggregater.
Vetscan Imagyst: AI-drevet digital skanner for blant annet blodutstryk
Digital skanner med AI-teknologi som erstatter manuell mikroskopering eller sending av blodutstryk til laboratorium - Gir en morfologi-tolkning direkte på din klinikk, innen minutter.
Hvorfor velge en komplett hematologi-løsning in-house på din klinikk?
Det åpenbare er jo for å kunne diagnostisere patologier, men å velge in-house diagnostisering handler også mye om å utelukke det verste og berolige dyreeiere om at Fido eller Pussi ikke har en alvorlig sykdom - på få minutter.
Diagnostisering med Vetscan Opticell™
Full hematologisk status inkludert retic, trombocytt-aggregater og en 5-parts differensial kan være til hjelp for å diagnostisere blant annet følgende:
- ulike typer anemier
- virusinfeksjoner kontra bakterielle infeksjoner
- ulike typer leukemier
- m.fl.

Diagnostisering med Vetscan Imagyst
Erstatter manuell mikroskopering av blodutstryk - helautomatisk, inkludert AI-drevet tolkning.
Supplerer en hematologisk status
- bekrefter celletelling fra et hematologi-instrument
- oppdager trombocyttaggregater
Diagnostisering av patologiske celler
- polykromatiske celler
- nRBC - kjerneholdige røde blodlegemer
- abormale cellemorfologier
- band cells / stavkjernede granulocytter

Vetscan Opticell™
Med innovativ Viscoelastic Focusing og AI-styrt bildeanalysering.
Viscoelastic Focusing teknologien gjør at cellene blir samlet i ett enkelt lag. Dette gjør det mulig å ta detaljerte bilder av cellene.
- Nøyaktighet sammenlignbar med referansemetode (Advia) takket være Viscoelastic Focusing-teknologien
- teller trombocytter utenpå trombocyttaggregater
- flagger ved abnormale celler
- Ingen reagenser å bytte - ingen kalibrering. Minimerer hands-on tid.
- Enkel tre-trinns prosedyre, med alt-i-ett testkassett - Minimerer feilkilder pga. reagenshåndtering
- Intet vedlikehold
- Oppkoblet til journalsystem via Vetscan Hub og Vettigo
Vestcan Imagyst
Vetscan Imagyst er en helautomatisk digital skanner som benytter AI-basert bildegjenkjenning for å granske morfologier av de ulike blodcellene på et blodutstryk.
- Erstatter manuell mikroskopering
- Gir ut klare bilder sammen med en detaljert rapport
- Veterinæren kan benytte seg av tjenesten The Virtual Laboratory og be om en second opinion ved å sende bildene og rapporten til Zoetis sine on-line-spesialister innen fagfeltet, når som helst på døgnet.
- Intet vedlikehold
- Vetscan kan i tillegg til blodustryk, brukes for:
- fekal flotasjon
- Urinsediment
- dermatologi
- cytologi
- AI-masses: detekterer potensielt kreftceller i vanlige lymfeknute‑ og hud/subkutane vevsprøver med rask, AI‑drevet cytologisk analyse.

Ta kontakt med en av våre produktsjefer for mer informasjon

